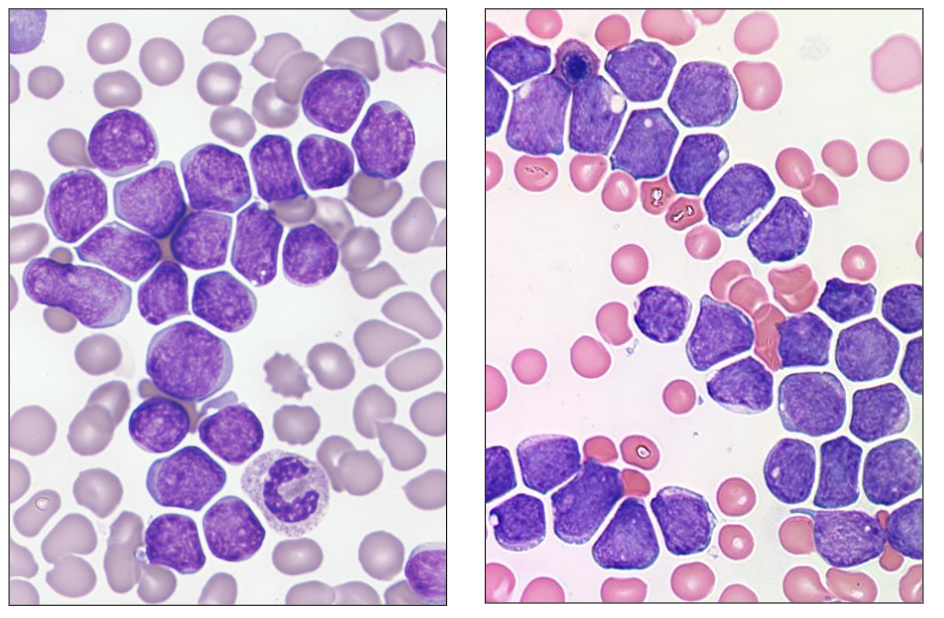
<p>- these dont hvae the hand mirror apperance other then one of them</p><p>- these are two different patients with ALL</p><p>- all the cells resemble one another (monomorphic = one morphology)</p>

(L12) IMED2002 - Acute Leukaemia - Blood Cancers 1
1/54
There's no tags or description
Looks like no tags are added yet.
Name | Mastery | Learn | Test | Matching | Spaced | Call with Kai |
|---|
No analytics yet
Send a link to your students to track their progress
55 Terms

Blood Cancers
There are many different types

Malignant White Blood Cell Disorders ("Blood Cancers")
- Uncontrolled proliferation of neoplastic (cancer) cell with an underlying clonal genetic defect
.
Acute:
- Precursor cell that fails to differentiate
- Without treatment: poor outlook
- With treatment: potentially curable
.
Chronic:
- Cells differentiate and resemble normal blood cells
- Without treatment: generally >5 year survival
- With treatment: some potentially curable (few)
.
- Lymphoid and myeloid

Incidence of Blood Cancers in Australia is Rising
DIAGRAM ON SLIDE 4


Age profile of Patients with Blood Cancers
DIAGRAM ON SLIDE 5

IMED2002 Lecture Series on Blood Cancers
- acute and chronic/lymphoid and myeloid
.
FOUR DIFFERENT DISEASE CATEGORIES
1. Acute leukaemia
2. Chronic leukaemia
3. Plasma cell myeloma
4. Lymphoma
.
- difference between acute and chronic is the acute leukaemias are the leukaemias that arise early in haemopoietic differentiation whereas chronic leukaemias probably arise in a early cell but the cells still have the ability to differentiate and resemble mature end stage normal cells
- morphologically, when you look at them in a microscope they dont exactly look normal just like hypogranular basophils but they do resemble a normal cell
- acute leukaemias do not resemble normal cell

Acute Leukaemia DIAGRAM
DIAGRAM ON SLIDE 7


Chronic Leukaemia DIAGRAM
DIAGRAM ON SLIDE 8


Myeloid Leukaemia DIAGRAM
DIAGRAM ON SLIDE 9


Lymphoid Leukaemia DIAGRAM
DIAGRAM ON SLIDE 10


Acute vs Chronic Leukaemia
DIAGRAM ON SLIDE 11


How is Leukaemia Diagnosed?
Four main test types:
1. Look: microscope
2. Blood "groups"
3. Chromosomes
4. DNA
.
- all are important
- al done individually
- all take time
- Information provides the diagnosis, prognosis, treatment


What is the most common age when people get a "blood cancer" (haematological malignancy)
- over 70 years
.
- the answer is in that graph at the start
- a short answer question could be why incidence is rising


1. ACUTE LEUKAEMIA DIAGRAM
- on the left is Acute Lymphoblastic Leukaemia
- On the right is Acute Myeloid Leukaemia


Acute Leukaemia: Overview
- Cause unknown
- Affects children and adults (increase with age)
- Replacement of marrow by leukaemic ("blast") cells
- Lymphoid or myeloid lineage
- Reduction in normal cells
- Treatment: chemotherapy; transplant
- "Supportive care": transfusions; antibiotics

Clinical Overview of Acute Leukaemia (Clinical Features, Symptoms, Signs)
Clinical features:
- Affects all ages (children: predominantly ALL)
.
Symptoms: Bone marrow failure
- Anaemia: Lethargy etc
- Leucopenia: Infections, fevers
- Thrombocytopenia: Bleeding, bruising
.
Signs: Tissues may be involved by leukaemia
- Organ enlargement: lymph nodes; spleen; skin
- Gum hypertrophy
Pathology of Acute Leukaemia
BM replaced by abnormal "blast" cells:
- Immature cells; fine chromatin, nucleolus
- Variable amounts of cytoplasm
- Have acquired genetic defect (chromosome; mutation)
- Proliferate; do not differentiate
- Released into blood: circulating blast cells; cytopenias (pancytopenia is the name)
.
Type of leukaemia determined by:
- Cell appearance (morphology)
- "Biomarkers" or cellular antigens
- Cell chromosomes

Morphology of Acute Leukaemia
- Blast (leukaemia) cells in the bone marrow
.
- on the left were have ALL: cells are intermediate size, and nucleus occupies majority of the cell, very little cytoplasm
- on the right we have AML: cells are bigger, more cytoplasm, no haemopoietic elements in the background apart from one neutrophil

Phenotype of Acute Leukaemia
- Test for antigens expressed by leukaemic cells
.
Cell "phenotype" determines lineage:
- B lineage: CD10, CD19, CD79a
- T lineage: CD2, CD3, CD7
- Myeloid: CD13, CD33, CD64, CD117
.
- Stage of differentiation (maturity): CD34, TdT
- Performed by flow cytometry or immunohistochemistry

Genetics of Acute Leukaemia
- Test for chromosomes
- Test for mutations
.
Methods performed:
- Karyotype: full chromosomal analysis
- Specific (FISH): fluorescence in situ hybridisation
- Mutations: PCR; massively parallel sequencing

Treatment: General principles - Acute leukaemia
- Aggressive cytotoxic chemotherapy
- Bone marrow transplantation (allo)
- Monoclonal antibody therapy
- Specific targeted inhibitors
- Side effects: Prolonged pancytopenia
- Cytokines (e.g. G-CSF)
- Supportive care: transfusions; antibiotics

In relation to acute leukaemia
- Can involve body organs
.
- it can be inherited, but its not "usually inherited"


Acute leukaemia is characterised by cells that are/have
- Genetic defect
.
- coarse chromatin is seen in mature cells, which we would see in chronic leukaemias


Which of the following biomarkers indicates leukaemia is of myeloid origin
- she didnt say the answer

1. Precursor Lymphoid Leukaemia
- Also called: Acute lymphoblastic leukaemia (ALL)
- Neoplastic proliferation of precursor cells committed to B or T lymphoid lineage (lymphoblastic leukaemia)
- Somatic mutation in progenitor cell
- Presentation: BM failure; organ infiltration
- Age: child or adult
- Diagnosis: blood and bone marrow examination
- Classification: phenotype, genetics
- Prognosis: child = good; adult = poor

Acute Lymphoblastic Leukaemia (ALL)
- Incidence rate: 3.4/100,000
.
Children:
- Most common cancer in children
- B-lineage ALL: 85% of ALL in children, Commonest leukaemia in children
- T-lineage ALL: 15% of ALL in children
- Childhood ALL: 90% cure
.
- Adults: poor prognosis; few cures


Clinical Features of ALL
Symptoms:
- Anaemia: Lethargy etc
- Leucopenia: Infections, fevers
- Thrombocytopenia: Bleeding, bruising
- "blast" cells: bone pain, weight loss, loss of appetite
.
Signs
- Enlarged liver and spleen (hepatomegaly and splenomegaly)due to organ infiltration
- Enlarged lymph nodes (lymphadenopathy)
- Pale, conjunctival pallor
- Bruises

Acute Lymphoblastic Leukaemia
Morphology of lymphoblasts in marrow & blood:
- Size: Slightly larger than lymphocyte to size of neutrophil - Cytoplasm: Scant; basophilic
- Nucleus: Round; may be convoluted (e.g. pre-T)
- Chromatin: Finely granular
- Nucleolus: Inconspicuous
- Granules: Usually nil
- Vacuoles: Precursor B and Burkitt
- Other: "Hand-mirror" morphology

Morphology of ALL
- these dont hvae the hand mirror apperance other then one of them
- these are two different patients with ALL
- all the cells resemble one another (monomorphic = one morphology)

Blast Cell Phenotype: ALL
- Flow cytometry to detect cell antigens associated with stage of differentiation and lineage
.
B-lineage ALL:
- CD10, CD19, cCD79a, TdT
- Usually CD34 positive
.
T-lineage ALL:
- CD2, CD3, CD7, TdT
- May express CD4 and / or CD8
- Usually CD34 negative


Chromosomes in ALL: prognosis
Cytogenetics: assess leukaemia cell genetics
- To assess the chromosomes in the leukaemia cells
- Correlate with prognosis (outcome)
- Hyperdiploidy
- t(9;22)
- t(12;21)
- t(1;19)
- t(4;11)


Cytogenetics of ALL by Age
- chromosomes change common in B-ALL and vary by age
.
- we can see children aged 1-4 have most of them have abnormalities on 12;21 translocation and orange is hyperdiploidy
- basically just look at each one and roughly say what abnormality is common for what age group


Survival and Cytogenetics
- Paediatric ALL: chromosomal changes and prognosis

ALL: Management Approaches
CYTOTOXIC THERAPY:
- To eradicate leukaemia: remission induction therapy
- Consolidation therapy (up to 3 years)
.
Supportive care:
- Transfusion: blood products red cells, platelets
- Control of infection: antibiotics; anti-fungals
.
Transplantation:
- Allogeneic (family member) or matched volunteer
- PB stem cells or bone marrow
- ALL after relapse (2nd remission)

In relation to acute lymphoblastic leukaemias
is most commonly CD-10 positive
- CD10 positive used to be called acute lymphoblastic leukaemia antigen thts present in B cell ALL


Acute lymphoblastic leukaemia in children
Usually occurs between 2 and 5 years of age


A 4 yr girl has newly diagnosed leukaemia. Based on her karyotype the prognosis is poor. True or false?
SHE SKIPPED THIS

2. Acute Myeloid Leukaemia
- AML: clonal defect in myeloblast
- Paediatric (rare) and adults
- Many subtypes with different morphology
- Immunophenotyping (antigen expression by flow cytometry) to characterise
.
Many genetic abnormalities:
- Chromosomal changes and point mutations
- t(8;21), t(15;17), inv(16); mutations NPM1
.
- Treatment: chemotherapy; transplantation
Morphology of AML
MYELOBLASTS:
- Size: Variable: slightly larger than lymphocyte to size of monocyte
- Cytoplasm: Moderate amount; basophilic to blue-grey
- Nucleus: Round to ovoid; may be indented
- Chromatin: Granular
- Nucleolus: Present; one or several
- Granules: Few to many azurophilic; Auer rods
- Vacuoles: Common; esp. monocytoid
.
- nuclear shape can vary significantly
- amount of cytoplasm is generally greater than in lymphoblastic leukaemia, and cells tend to have nucleolus
- blasts will commonly have granules
- other feature is Auer Rod

Acute Myeloid Leukaemia
- the linear structure in the cells called auer rods
- if we see auer rods we can say that this is acute myeloid leukaemia, you do not see it in ALL
- other features: cells tend to be larger then lymphoblasts in ALL, nucleus shape is more variable, amount of cytoplasm is variable (lower nuclear to cytoplasm ratio)
- cells have light purple chromatin nuclear colour
- some cells have nucleolus (pale staining region present in nucleus)
.
- some examples dont have auer rods, but more common feature is granules prsent in cytoplasm


Acute Myeloid Leukaemia - Myeloblasts with Cytoplasmic Granules
- can see pink granules present in cytoplasm


Acute Myeloid Leukaemia - Some Morphologies
- different morphological subtypes of acute myeloid leukaemia


Where is the Auer Rod
- top left cell
- somewhere in the middle you can see as well


Blast Cell Phenotype: AML
- Antigen expression profile by flow cytometry
- Myeloid antigens: CD13, CD33
- Monocytoid: CD14, CD64
- Primitive cells: CD34 (commonly positive)
.
- have to remember some CD numbers
- CD34 (haemopoietic stem cells)
- CD13 and CD33 are myeloid associated antigens
- if you have a leukaemia that is positive for CD13 and CD33 monoclonal antibodies, it tells us the cell is myeloid
- CD10 and CD19 are B cells associated (would be positive particularly in paediatric B cell acute lymphoblastic leukaemia)
- CD3 and CD7 are T cells associated


Chromosomes in AML: prognosis
- Good (favourable) prognosis: t(15,17), t(8,21); t(16,16)
- Intermediate prognosis: normal karyotype
- Poor (adverse) prognosis: monosomy 3, 5 and 7
.
- Prognosis classification (good, intermediate, poor) categorizes disease outlook, typically in cancer, based on survival statistics and treatment response. Good indicates a high likelihood of recovery/cure. Intermediate suggests moderate risk, needing standard treatment. Poor implies a lower chance of recovery, often needing aggressive, intensive therapy


AML Cytogenetics
- t(8;21)(q22;q22) RUNX1::RUNX1T1
- Approximately 5% AML. Generally young patients. Leukaemic blast cells have cytoplasmic granules. Favourable prognosis (likely to achieve complete remission)


Acute Promyelocytic Leukaemia
- Age: any (20-60 yrs most common)
.
Morphology:
- Blast cells: promyelocyte morphology
- Granules and Auer rods ("faggot" cells)
- CD34-negative; CD33 positive
.
Coagulation:
- DIC; hypofibrinogenaemia
.
Genetics:
- t(15;17) PML:: RARA
.
Therapy:
- All-trans Retinoic acid - Arsenic trioxide
.
- Prognosis: Good
- "faggot" is from old english meaning bundle of sticks
.
- the reason that vitamin A (Retinoic acid) worked well is because the genetic abnormality involving chromosomes 15 and 17 involves the retinoic acid receptor gene, and by giving on retinoic acid, we can sometimes overcome the effect of that translocation


APML Cytogenetics
- t(15;17) PML::RARA


AML: Molecular Genetics
- Increasing use of DNA testing: prognosis; treatment
- Next-generation sequencing
- Provide important prognostic information for further risk stratification, especially intermediate risk group
- Many mutations (1-4 per case)
- Good prognosis: NPM1
- Poor prognosis: FLT3
- Targeted therapy: FLT3; IDH1

AML: Management Approaches
Cytotoxic therapy:
- Remission induction therapy
- Consolidation therapy
- New targeted therapies in clinical trial
.
Supportive care:
- Transfusion: blood products red cells, platelets
- Control of infection: antibiotics; anti-fungals
.
Transplantation: < 65 years AML in remission
- Allogeneic; matched volunteer
- PB stem cells or bone marrow
Cytotoxic Therapy
Combination chemotherapy
- Destroy leukaemia cells
- But also damages the normal cells
- Induces bone marrow failure (as it damages any cell that is undergoing cell division)
- Aim for remission: - Absence of detectable leukaemia (morphology; mutation), Return of normal marrow function
.
Supported with:
- Blood products (packed red cells; platelets)
- Anti-microbial; anti-fungal treatments

Acute myeloid leukaemia is
- usually occurs in adults over 60 years of age


Karyotype of leukaemic cells from a 23-year old female. Based on this, the prognosis is likely to be good:True or False?
dont know, she skipped


Which of the following are good prognostic genetic alterations in acute myeloid leukaemia?
- NPM1 mutation


Summary: ALL vs AML
DIAGRAM ON SLIDE 55


Learning Outcomes
DIAGRAM ON SLIDE 56
